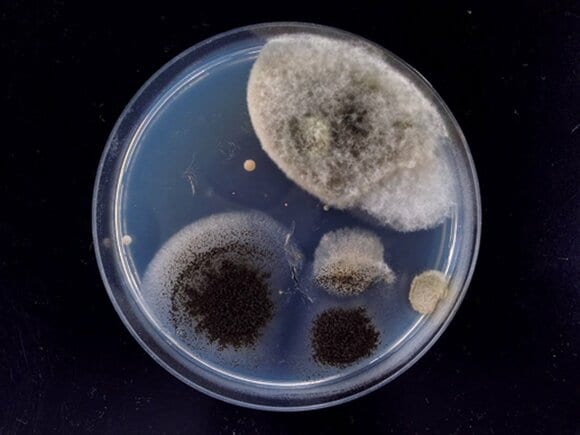
蛇口の先端部分のカビ
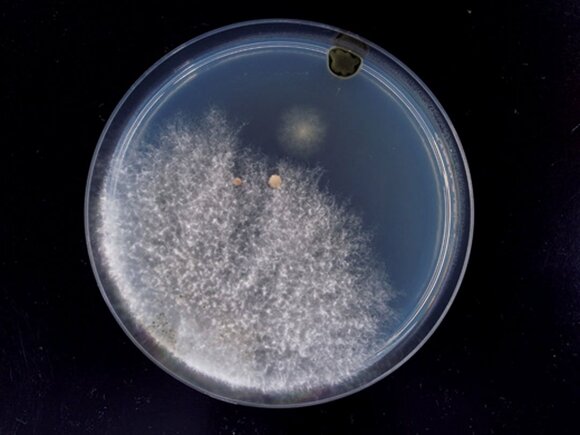
換気扇内のカビ

梅雨どきは、水回りのカビ・ダニが気になってしまいますね。住環境はもちろんのこと、健康被害への危険性もあるカビ・ダニ。ESSEレポーターHさんのお宅をカビ・ダニ博士の川上裕司さんが訪問し、見落としがちな場所をチェックし、危険度を徹底分析。さらに、予防、退治法を掃除のプロ・高橋敬子さんに聞きました。
仰天! トイレの蛇口や換気扇はカビの温床だった!
<トイレの水栓>水アカとホコリが付着し、カビが発生するおそれアリ
トイレの水栓を調べてもらったところ、かなり衝撃的な結果に。「蛇口の先端部分にアレルギーの原因となるクロコウジカビなどを検出。そのまま使用すると手から汚染する危険がありますよ」とのこと…。
すべての画像を見る(全4枚)また、トイレの手洗いボウルのほうは、水アカやホコリが混じった汚れがつきがちです。とりわけ水栓の先にカルキ汚れが付着すると、カビや細菌が繁殖します。「こんなところにもカビがいるなんて」とHさんは愕然としていました。
【退治法】
布に消毒用エタノールをつけてふき、水でかたく絞った布でふき取ります。白いこびりつきがある場合はカルキ汚れなので、クエン酸水をつけた布で緩め、落としてください。
【予防法】
ホコリがたまらないよう、週に一度は水栓回りを掃除。水でかたく絞った布で全体をふき取り、水栓の先は古歯ブラシなどを使って細かな汚れをかき落としましょう。
<換気扇>内部でカビが増殖している可能性が。定期的な掃除は必須
換気扇を調べたところ、タイル目地や繊維などあらゆるものを黒く汚染し、劣化させるクロカビや酵母菌などを検出しました。「換気扇内はさらに繁殖している可能性が大きいです」と川上さん。
水滴やホコリを吸い込む換気扇は、「一見汚れていなくても、内部はホコリだらけの可能性大。カビを浴室内にまき散らしていることになります」という川上さんの指摘に、「大掃除のときに外側をふくくらいでした!」とHさんはショックを隠せない様子。
【退治法】
換気扇のフタを外し、消毒用エタノールをつけた布で換気扇の内部とフタ裏の汚れをふき取ります。フタは水でよく洗い、十分に乾燥させてからセットしてください。
【予防法】
月に一度は、消毒用エタノールをつけた布で換気扇の外側をふき取り、殺菌する習慣に。半年に一度は、換気扇のフタを外し、たまったホコリを掃除機で吸い取ります。
※本記事はESSE2015年7月号の記事を抜粋したものです